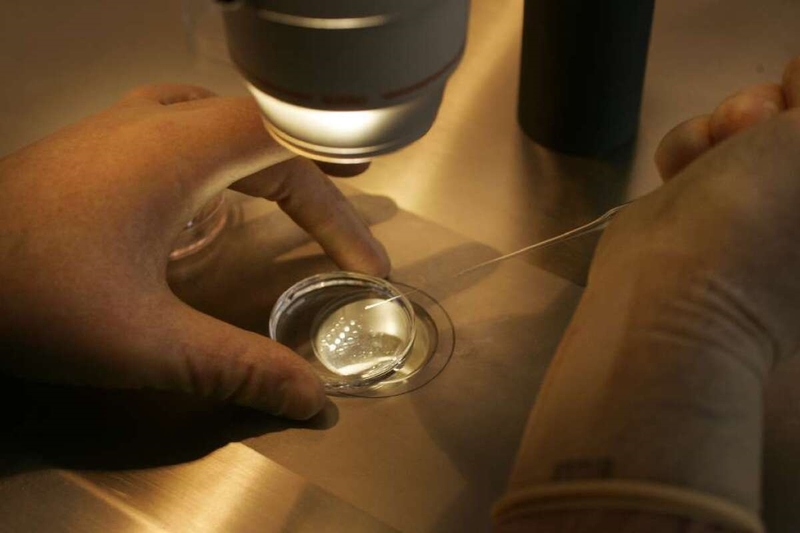
Tìm hiểu chi tiết về hiến trứng: Quy trình, điều kiện, quyền lợi và lưu ý 3

Tốt nghiệp Đại học Y Dược TP. Hồ Chí Minh. Có nhiều năm trong lĩnh vực dược phẩm. Hiện đang là giảng viên cho Dược sĩ tại Nhà thuốc Long Châu.
Thanh Hương
03/08/2024
Mặc định
Lớn hơn
Hiến trứng đây là một cơ hội để những người phụ nữ khỏe mạnh sẻ chia và mang lại niềm hạnh phúc làm mẹ cho những người phụ nữ khác. Bài viết này sẽ giúp bạn hiểu rõ hơn về quá trình hiến tặng trứng, những điều kiện cần thiết và những vấn đề cần cân nhắc trước khi quyết định.
Hiến tặng trứng, một hành động cao đẹp và đầy ý nghĩa, mở ra cơ hội làm cha mẹ cho những cặp vợ chồng hiếm muộn. Tuy nhiên, đây cũng là một quyết định quan trọng, đòi hỏi sự cân nhắc kỹ lưỡng về nhiều mặt, từ sức khỏe, tâm lý đến đạo đức. Bài viết này sẽ cung cấp thông tin chi tiết về hiến tặng trứng, giúp bạn hiểu rõ hơn về quy trình, điều kiện, quyền lợi và nghĩa vụ của người hiến trứng, cũng như những vấn đề cần lưu ý trước khi đưa ra quyết định.
Hiến trứng là quá trình một người phụ nữ (người hiến trứng) cung cấp trứng của mình cho một người phụ nữ khác (người nhận trứng) để giúp họ có con thông qua các phương pháp hỗ trợ sinh sản. Người hiến trứng thường là những phụ nữ trẻ, khỏe mạnh, có khả năng sinh sản tốt và không mắc các bệnh di truyền.
Hiến tặng trứng là một hành động cao đẹp, mang ý nghĩa nhân văn sâu sắc, giúp các cặp vợ chồng hiếm muộn thực hiện ước mơ làm cha mẹ. Ý nghĩa của hiến tặng trứng còn là đóng góp vào sự phát triển của y học sinh sản. Trứng hiến tặng có thể được sử dụng trong nghiên cứu khoa học, giúp tìm ra những phương pháp điều trị mới cho các trường hợp vô sinh hiếm muộn.

Quy trình hiến trứng thường bao gồm các bước sau:
Người hiến trứng sẽ được kiểm tra sức khỏe tổng quát, bao gồm xét nghiệm máu, nước tiểu, siêu âm và các xét nghiệm khác để đảm bảo không mắc các bệnh truyền nhiễm hoặc di truyền. Đồng thời, người hiến trứng sẽ được tư vấn về quy trình hiến trứng, rủi ro và lợi ích của việc hiến tặng trứng cũng như các vấn đề pháp lý liên quan.
Người hiến trứng sẽ được tiêm thuốc kích trứng - loại thuốc có tác dụng kích thích buồng trứng để sản xuất nhiều trứng hơn bình thường nhằm mục đích thu hoạch được nhiều trứng hơn trong quá trình chọc hút. Quá trình kích trứng thường kéo dài khoảng 10 - 14 ngày và được theo dõi chặt chẽ bằng siêu âm.
Chọc hút trứng được tiến hành khi trứng trong buồng trứng của người hiến đã trưởng thành. Đây là một thủ thuật đơn giản, được thực hiện dưới gây mê hoặc gây tê tại chỗ. Bác sĩ sẽ sử dụng một kim nhỏ để chọc qua thành âm đạo và hút trứng ra khỏi buồng trứng.

Trứng sau khi được lấy từ người hiến sẽ được kiểm tra kỹ lưỡng về hình thái, kích thước và chất lượng di truyền. Chỉ những trứng đạt tiêu chuẩn mới được đưa vào lưu trữ ở ngân hàng trứng. Mỗi mẫu trứng được gắn mã số riêng biệt, thông tin về người hiến trứng được bảo mật tuyệt đối và chỉ được sử dụng cho mục đích y tế. Trứng được bảo quản trong nitơ lỏng ở nhiệt độ cực thấp (-196 độ C) để duy trì chất lượng và khả năng thụ tinh trong thời gian dài.
Ai có thể sử dụng trứng từ ngân hàng? Đó là những phụ nữ không có khả năng sản xuất trứng do các nguyên nhân như suy buồng trứng sớm, mãn kinh sớm, phẫu thuật cắt bỏ buồng trứng… Phụ nữ có nguy cơ di truyền bệnh lý cho con cái cũng có thể sử dụng trứng hiến tặng từ người khỏe mạnh để giảm thiểu nguy cơ di truyền bệnh sang con.
Những đối tượng này có thể sử dụng trứng hiến tặng kết hợp với tinh trùng hiến tặng để có con. Các cặp vợ chồng hiếm muộn cũng có thể dùng trứng hiến tặng khi các phương pháp điều trị khác không thành công.
Trứng sau khi được lấy ra sẽ được thụ tinh với tinh trùng của người chồng/bạn tình của người nhận trứng hoặc tinh trùng hiến tặng trong phòng thí nghiệm bằng phương pháp thụ tinh ống nghiệm (IVF).
Muốn hiến tặng trứng, người phụ nữ cần đảm bảo các điều kiện cần và đủ dưới đây:

Hiến tặng trứng là nghĩa cử cao đẹp đi kèm với những quyền lợi cụ thể cho người hiến trứng như:
Bên cạnh những quyền lợi, người hiến trứng cũng có những nghĩa vụ quan trọng cần thực hiện như:

Quyết định hiến tặng trứng là một quyết định quan trọng đòi hỏi sự cân nhắc kỹ lưỡng về nhiều mặt. Quá trình hiến trứng có thể gây ra một số tác dụng phụ do việc sử dụng thuốc kích thích buồng trứng như: Đau bụng, buồn nôn, đầy hơi, hội chứng quá kích buồng trứng… Người hiến trứng có thể trải qua những cảm xúc phức tạp khi chia sẻ thông tin cá nhân và tiền sử bệnh tật của mình. Bằng cách cân nhắc kỹ lưỡng những vấn đề trên, bạn có thể đưa ra quyết định đúng đắn và có ý nghĩa nhất cho bản thân và những người xung quanh.
Dược sĩ Đại họcNguyễn Vũ Kiều Ngân
Tốt nghiệp Đại học Y Dược TP. Hồ Chí Minh. Có nhiều năm trong lĩnh vực dược phẩm. Hiện đang là giảng viên cho Dược sĩ tại Nhà thuốc Long Châu.